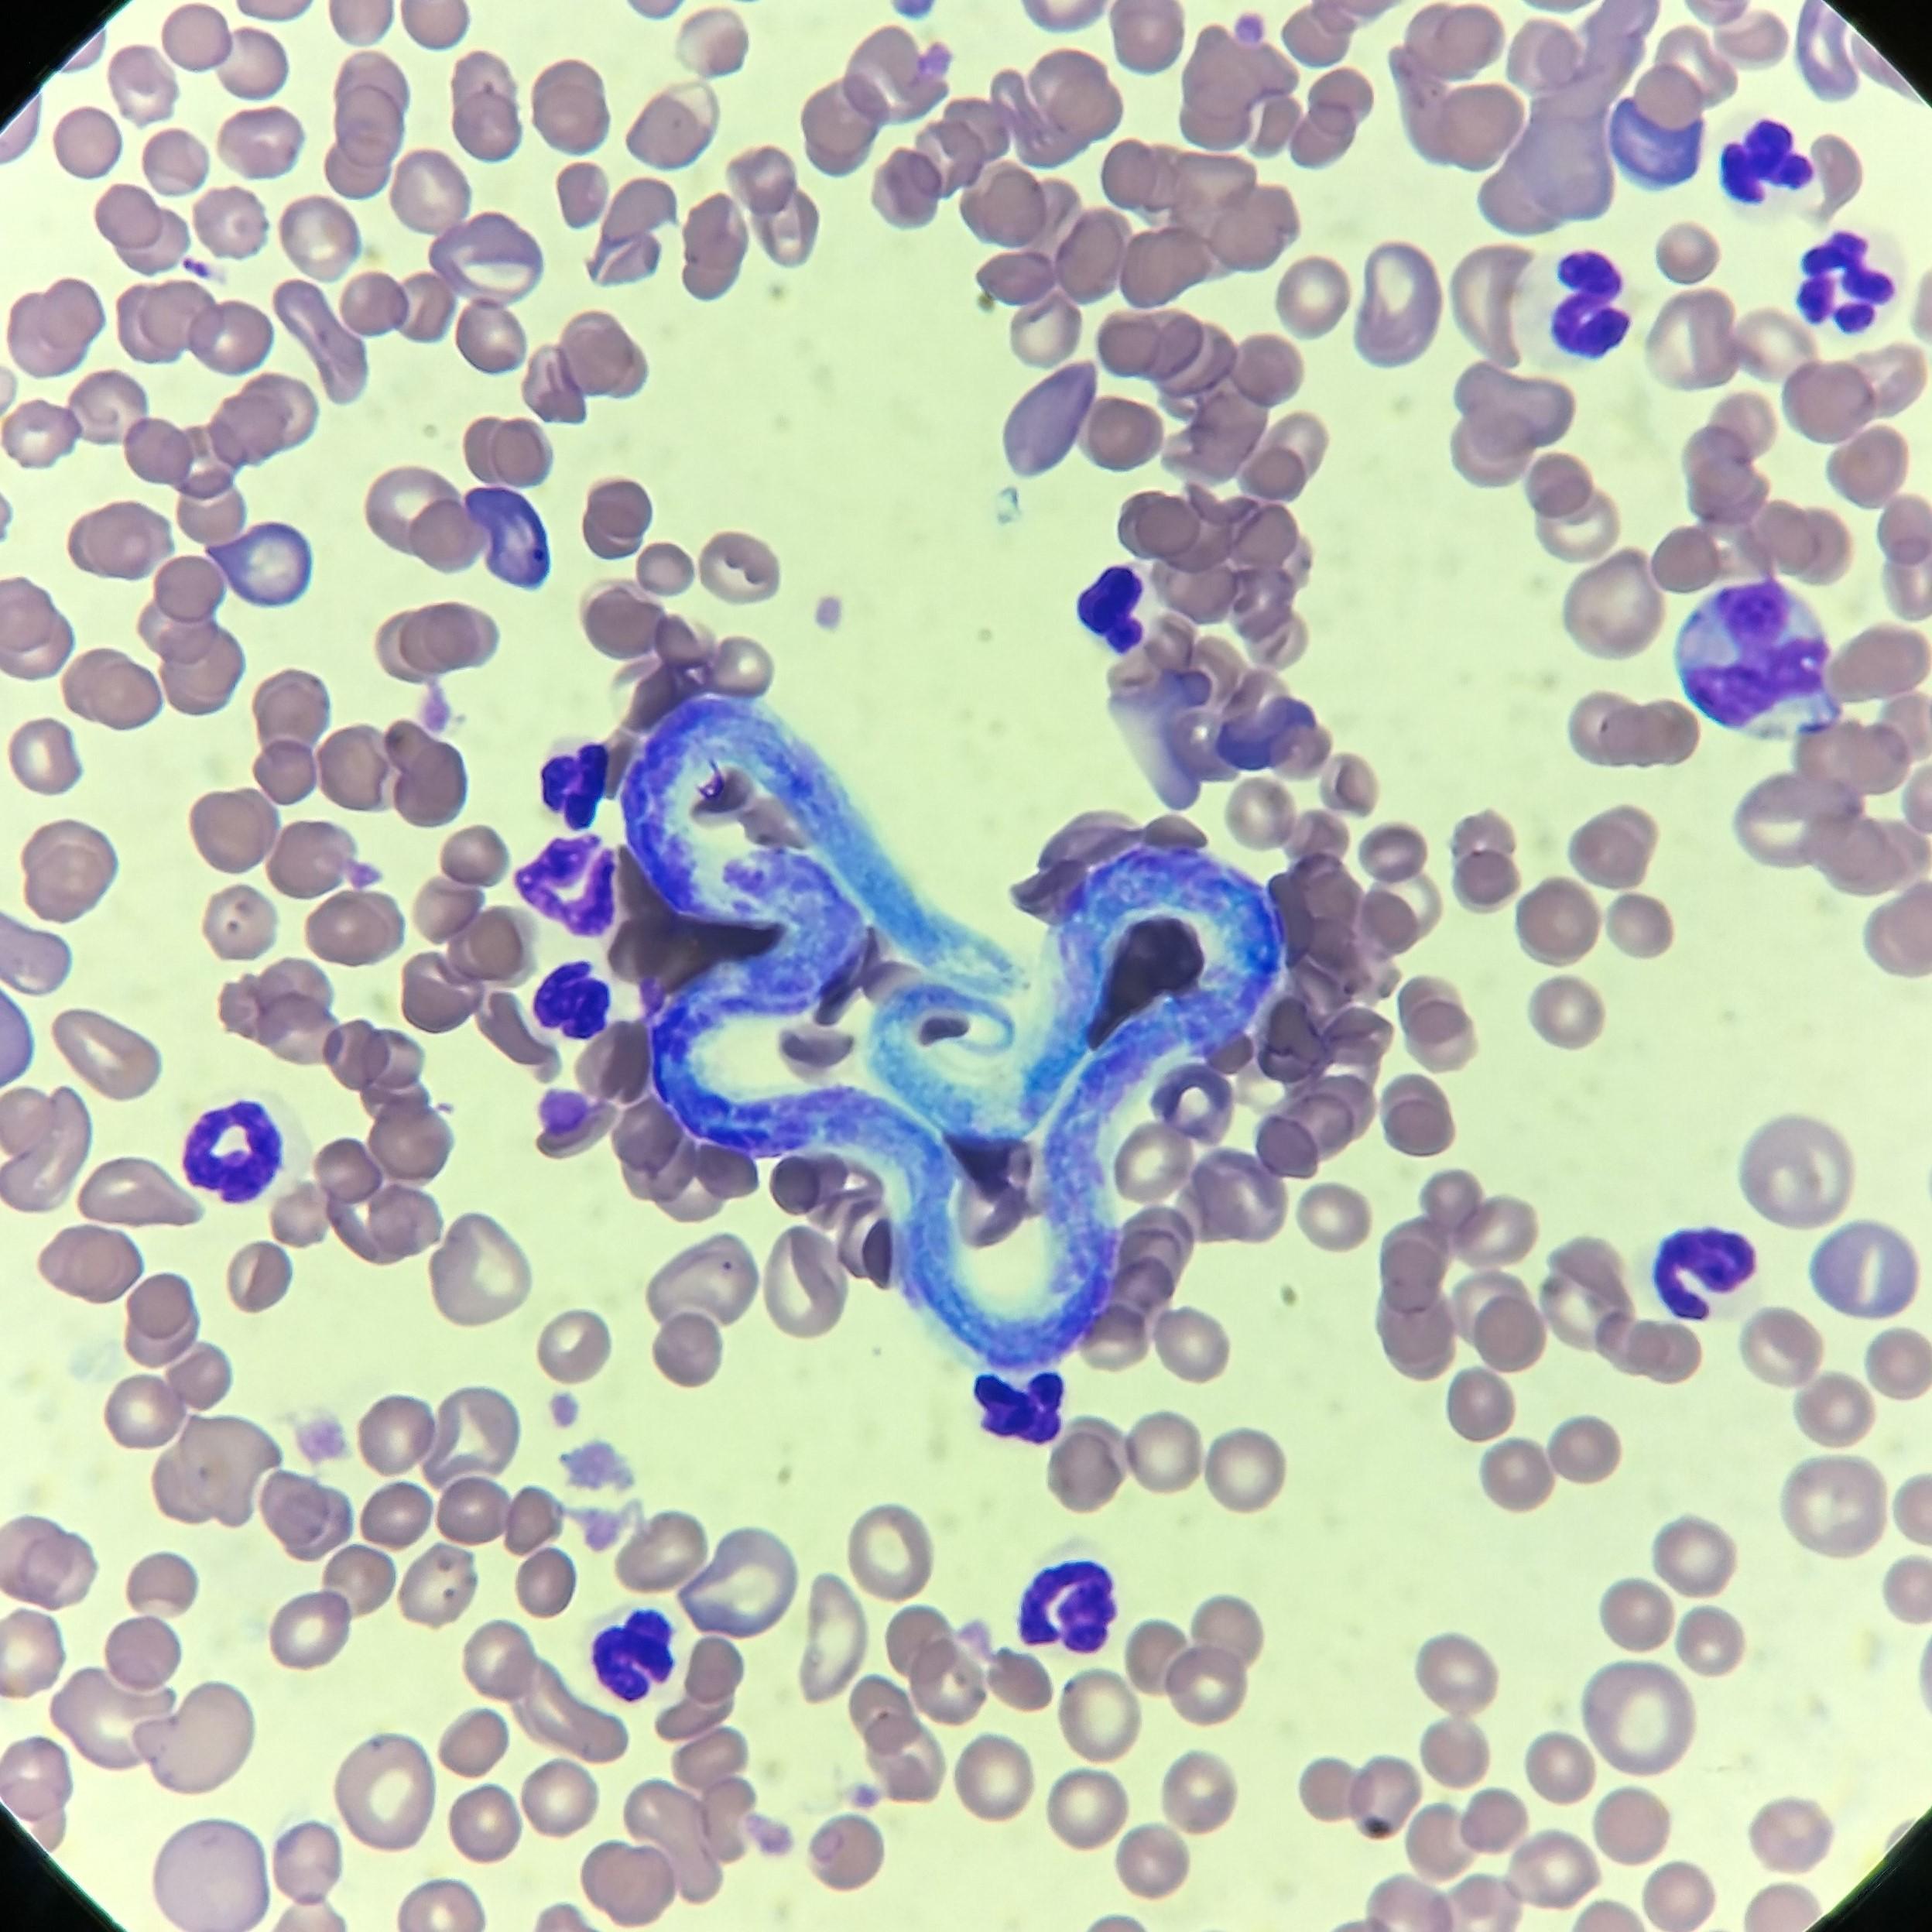

Filariozy w Polsce
W Polsce od pewnego czasu endemicznie występuje Dirofilaria repens, będąca przyczyną dirofilariozy skórnej. Fakt ten jest już dobrze znany i nie stanowi większego zaskoczenia. Notuje się również pojedyncze przypadki zarażenia Dirofilaria immitis, czynnika etiologicznego robaczycy serca. W większości przypadków pasożyt ten jest jednak zawleczony do Polski z terenów endemicznych, co wiąże się z przemieszczaniem się zwierząt domowych wraz z ich właścicielami.
W 2020 roku w laboratorium Vetlab wykryto pierwszy w Polsce przypadek zarażenia innym gatunkiem nicienia o podobnym cyklu rozwojowym – Acanthocheilonema dracunculoides, który dotychczas występował głównie w południowej Europie, Afryce i Azji. Sytuacja ta pokazuje, że zmiany klimatyczne mogą wpływać na pojawianie się w naszym kraju chorób wektorowych, dotychczas rzadko lub wcale nienotowanych. Z tego względu zachowanie czujności diagnostycznej jest niezwykle istotne.
Diagnostyka mikrofilariemii – od czego zacząć?
Jak zatem dobrze „rozegrać partię” z mikrofilariami, aby niczego nie przeoczyć?
Wstępnym etapem diagnostycznym jest test Knotta. Metoda ta, wykorzystując zagęszczenie próbki i lizę erytrocytów, pozwala wykryć obecność mikrofilarii we krwi. Charakteryzuje się ona wyższą czułością niż klasyczny rozmaz krwi, w którym mikrofilarie stwierdzane są raczej incydentalnie. Zaleca się pobieranie krwi do badania w godzinach wieczornych, ponieważ wtedy wykrywa się najwyższą liczbę pasożytów.
Warto pamiętać, że mikrofilarie są larwalnymi postaciami rozwojowymi. Ich obecność we krwi jest możliwa dopiero po osiągnięciu dojrzałości płciowej przez dorosłe pasożyty. W zależności od gatunku okres ten trwa zazwyczaj kilka miesięcy od momentu zarażenia.
W przypadku potwierdzenia mikrofilariemii zaleca się wykonanie badania metodą PCR, które umożliwia różnicowanie gatunków: Dirofilaria repens i Dirofilaria immitis oraz Acanthocheilonema dracunculoides i A. reconditum.
Dodatkowo do wykrywania zarażenia D. immitis można wykorzystać badanie na obecność antygenów, który wykrywa glikoproteiny układu rozrodczego samic. Należy jednak pamiętać, że w przypadku inwazji wyłącznie osobnikami męskimi wynik tego badania będzie ujemny.
Co zrobić w sytuacji, gdy pomimo wykrycia mikrofilarii we krwi wynik badania PCR oraz testu antygenowego w kierunku Dirofilaria immitis są ujemne?
W takim przypadku należy brać pod uwagę inwazję mniej typowymi pasożytami, na przykład niepatogennymi nicieniami z rodzaju Acanthocheilonema. Potwierdzenie takiego podejrzenia umożliwia typizacja mikrofilarii. Metoda ta, wykorzystując barwienie kwaśną fosfatazą, poszerza diagnostykę o dodatkowe gatunki filarii i pozwala na precyzyjne rozpoznanie.
Podsumowanie
Filariozy stanowią coraz istotniejsze wyzwanie diagnostyczne również w Polsce, co jest związane zarówno z przemieszczaniem się zwierząt, jak i postępującymi zmianami klimatycznymi sprzyjającymi chorobom wektorowym. Choć najczęściej rozpoznawane są inwazje Dirofilaria repens oraz sporadycznie Dirofilaria immitis, należy pamiętać także o mniej typowych gatunkach, takich jak Acanthocheilonema dracunculoides czy A. reconditum. Skuteczna diagnostyka mikrofilariemii wymaga podejścia etapowego – od testu Knotta, przez badania PCR i testy antygenowe, aż po typizację mikrofilarii w przypadkach niejednoznacznych. Zachowanie czujności diagnostycznej oraz właściwy dobór metod badawczych pozwalają na trafne rozpoznanie i wdrożenie odpowiedniego postępowania terapeutycznego.
Kategorie wpisów
- Alergologia (7)
- Biochemia (1)
- Cytologia (5)
- Hipiatria (4)
- Histopatologia (1)
- Immunologia (1)
- Mikrobiologia (2)
- Nefrologia (1)
- Parazytologia (2)